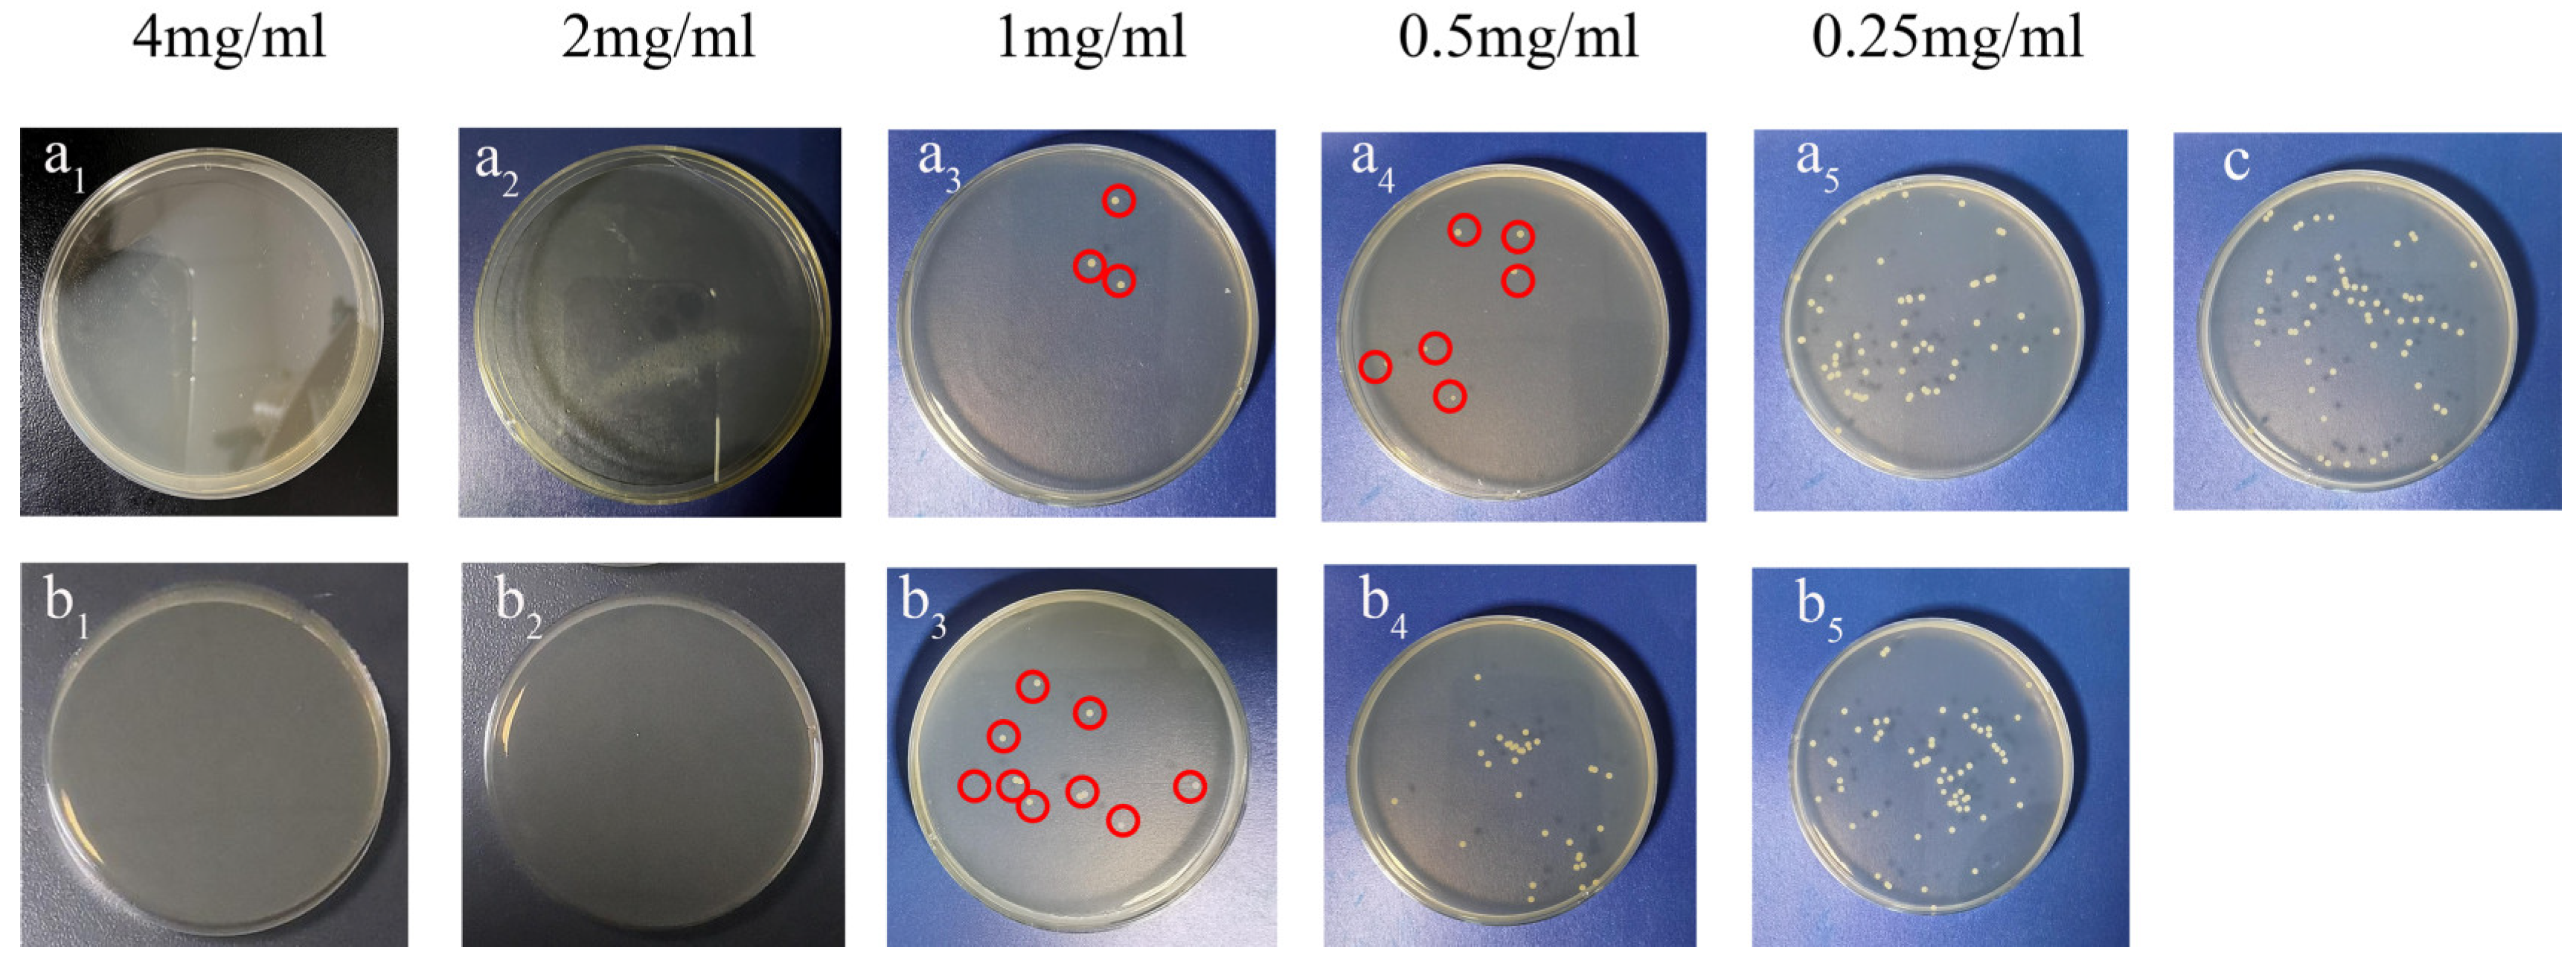
Nanomaterials 13 01384 g009 Nanomaterials 13 01384 g009

Utilizing Imine Bonds to Create a Self-Gated Mesoporous Silica Material with Controlled Release and Antimicrobial Properties
Abstract
1. Introduction
2. Materials and Methods
2.1. Materials
2.2. Synthesis of Hollow Mesoporous Silica Spheres (HMSS)
2.3. Fabrication of Amino-Modified HMSS (M-NH2)
2.4. Loading and Capping of Citral (CIT) on M-NH2 (M-NH2-CIT@CIT) and HMSS (M-CIT)
2.5. Characterizations
2.6. Plotting CIT Standard Curve
2.7. pH-Dependent CIT Release
2.8. Culture Conditions and Bacterial Strain
2.9. Antibacterial Activity Assays In Vitro
- A: Number of colonies in the control group
- B: Number of sample colonies.
2.10. Sterilization Mechanism
2.11. Data Processing
3. Results and Discussion
3.1. Characterization Results
3.2. The Determination of CIT Standard Curve
3.3. pH-Dependent Drug Release
3.4. Analysis of Antibacterial Activity In Vitro
3.5. Antibacterial Mechanism
4. Conclusions
Author Contributions
Funding
Data Availability Statement
Acknowledgments
Conflicts of Interest
References
- Sarengaowa; Hu, W.; Feng, K.; Jiang, A.; Xiu, Z.; Lao, Y.; Li, Y.; Long, Y. An in situ-Synthesized Gene Chip for the Detection of Food-Borne Pathogens on Fresh-Cut Cantaloupe and Lettuce. Front. Microbiol. 2019, 10, 3089. [Google Scholar] [CrossRef]
- Kuhn, D.; Ziem, R.; Scheibel, T.; Buhl, B.; Vettorello, G.; Pacheco, L.A.; Heidrich, D.; Kauffmann, C.; de Freitas, E.M.; Ethur, E.M.; et al. Antibiofilm activity of the essential oil of Campomanesia aurea O. Berg against microorganisms causing food borne diseases. LWT-Food Sci. Technol. 2019, 108, 247–252. [Google Scholar] [CrossRef]
- Llarena, A.K.; Taboada, E.; Rossi, M. Whole-Genome Sequencing in Epidemiology of Campylobacter jejuni Infections. J. Clin. Microbiol. 2017, 55, 1269–1275. [Google Scholar] [CrossRef]
- El-Tarabily, K.A.; El-Saadony, M.T.; Alagawany, M.; Arif, M.; Batiha, G.E.; Khafaga, A.F.; Elwan, H.A.; Elnesr, S.S.; Abd El-Hack, M.E. Using essential oils to overcome bacterial biofilm formation and their antimicrobial resistance. Saudi J. Biol. Sci. 2021, 28, 5145–5156. [Google Scholar] [CrossRef]
- Tabasum, H.; Bhat, B.A.; Sheikh, B.A.; Mehta, V.N.; Rohit, J.V. Emerging perspectives of plant-derived nanoparticles as effective antimicrobial agents. Inorg. Chem. Commun. 2022, 145, 110015. [Google Scholar] [CrossRef]
- Zhao, Y.; An, J.; Su, H.; Li, B.; Liang, D.; Huang, C. Antimicrobial food packaging integrating polysaccharide-based substrates with green antimicrobial agents: A sustainable path. Food Res. Int. 2022, 155, 111096. [Google Scholar] [CrossRef]
- Myint, K.Z.; Yu, Q.; Qing, J.; Zhu, S.; Shen, J.; Xia, Y. Botanic antimicrobial agents, their antioxidant properties, application and safety issue. Food Packag. Shelf Life 2022, 34, 100924. [Google Scholar] [CrossRef]
- Rasool, N.; Saeed, Z.; Pervaiz, M.; Ali, F.; Younas, U.; Bashir, R.; Bukhari, S.M.; Mahmood khan, R.R.; Jelani, S.; Sikandar, R. Evaluation of essential oil extracted from ginger, cinnamon and lemon for therapeutic and biological activities. Biocatal. Agric. Biotechnol. 2022, 44, 102470. [Google Scholar] [CrossRef]
- Weisany, W.; Samadi, S.; Tahir, N.A.-R.; Amini, J.; Hossaini, S. Nano-encapsulated with mesoporous silica enhanced the antifungal activity of essential oil against Botrytis cinerea (Helotiales; Sclerotiniaceae) and Colletotrichum nymphaeae (Glomerellales; Glomerellaceae). Physiol. Mol. Plant Pathol. 2022, 122, 101902. [Google Scholar] [CrossRef]
- Zhang, R.F.; Cui, Y.J.; Cheng, M.; Guo, Y.L.; Wang, X.Y.; Wang, J. Antifungal activity and mechanism of cinnamon essential oil loaded into mesoporous silica nanoparticles. Ind. Crops Prod. 2021, 171, 113846. [Google Scholar] [CrossRef]
- Bahrami, A.; Delshadi, R.; Jafari, S.M. Active delivery of antimicrobial nanoparticles into microbial cells through surface functionalization strategies. Trends Food Sci. Technol. 2020, 99, 217–228. [Google Scholar] [CrossRef]
- Ahmed, H.; Gomte, S.S.; Prathyusha, E.; Prabakaran, A.; Agrawal, M.; Alexander, A. Biomedical applications of mesoporous silica nanoparticles as a drug delivery carrier. J. Drug Deliv. Sci. Technol. 2022, 76, 103729. [Google Scholar] [CrossRef]
- Huang, P.; Lian, D.Z.; Ma, H.L.; Gao, N.S.; Zhao, L.M.; Luan, P.; Zeng, X.W. New advances in gated materials of mesoporous silica for drug controlled release. Chin. Chem. Lett. 2021, 32, 3696–3704. [Google Scholar] [CrossRef]
- Gulin-Sarfraz, T.; Kalantzopoulos, G.N.; Pettersen, M.K.; Asli, A.W.; Tho, I.; Axelsson, L.; Sarfraz, J. Inorganic Nanocarriers for Encapsulation of Natural Antimicrobial Compounds for Potential Food Packaging Application: A Comparative Study. Nanomaterials 2021, 11, 379. [Google Scholar] [CrossRef]
- Zeng, X.W.; Liu, G.; Tao, W.; Ma, Y.; Zhang, X.D.; He, F.; Pan, J.M.; Mei, L.; Pan, G.Q. A Drug-Self-Gated Mesoporous Antitumor Nanoplatform Based on pH-Sensitive Dynamic Covalent Bond. Adv. Funct. Mater. 2017, 27, 1605985. [Google Scholar] [CrossRef]
- Sun, R.J.; Wang, W.Q.; Wen, Y.Q.; Zhang, X.J. Recent Advance on Mesoporous Silica Nanoparticles-Based Controlled Release System: Intelligent Switches Open up New Horizon. Nanomaterials 2015, 5, 2019–2053. [Google Scholar] [CrossRef] [PubMed]
- Yoplac, I.; Vargas, L.; Robert, P.; Hidalgo, A. Characterization and antimicrobial activity of microencapsulated citral with dextrin by spray drying. Heliyon 2021, 7, e06737. [Google Scholar] [CrossRef] [PubMed]
- Cadena, M.B.; Preston, G.M.; Van der Hoorn, R.A.L.; Townley, H.E.; Thompson, I.P. Species-specific antimicrobial activity of essential oils and enhancement by encapsulation in mesoporous silica nanoparticles. Ind. Crops Prod. 2018, 122, 582–590. [Google Scholar] [CrossRef]
- Akbarian, M.; Gholinejad, M.; Mohammadi-Samani, S.; Farjadian, F. Theranostic mesoporous silica nanoparticles made of multi-nuclear gold or carbon quantum dots particles serving as pH responsive drug delivery system. Microporous Mesoporous Mater. 2022, 329, 111512. [Google Scholar] [CrossRef]
- Mu, M.; Shu, Q.L.; Xu, Z.H.; Zhang, X.; Liu, H.; Zhao, S.J.; Zhang, Y.M. pH-responsive, salt-resistant, and highly stable foam based on a silicone-containing dynamic imine surfactant. J. Mol. Liq. 2023, 374, 121236. [Google Scholar] [CrossRef]
- Muriel-Galet, V.; Perez-Esteve, E.; Ruiz-Rico, M.; Martinez-Manez, R.; Barat, J.M.; Hernandez-Munoz, P.; Gavara, R. Anchoring Gated Mesoporous Silica Particles to Ethylene Vinyl Alcohol Films for Smart Packaging Applications. Nanomaterials 2018, 8, 865. [Google Scholar] [CrossRef]
- Li, T.; Geng, T.; Md, A.; Banerjee, P.; Wang, B. Novel scheme for rapid synthesis of hollow mesoporous silica nanoparticles (HMSNs) and their application as an efficient delivery carrier for oral bioavailability improvement of poorly water-soluble BCS type II drugs. Colloids Surf. B Biointerfaces 2019, 176, 185–193. [Google Scholar] [CrossRef]
- Ribes, S.; Ruiz-Rico, M.; Perez-Esteve, E.; Fuentes, A.; Barat, J.M. Enhancing the antimicrobial activity of eugenol, carvacrol and vanillin immobilised on silica supports against Escherichia coli or Zygosaccharomyces rouxii in fruit juices by their binary combinations. LWT-Food Sci. Technol. 2019, 113, 108326. [Google Scholar] [CrossRef]
- Kumari, P.; Raza, W.; Meena, A. Lemongrass derived cellulose nanofibers for controlled release of curcumin and its mechanism of action. Ind. Crops Prod. 2021, 173, 114099. [Google Scholar] [CrossRef]
- Shen, K.-S.; Shu, M.; Tang, M.-X.; Yang, W.-Y.; Wang, S.-C.; Zhong, C.; Wu, G.-P. Molecular cloning, expression and characterization of a bacteriophage JN01 endolysin and its antibacterial activity against E. coli O157:H7. LWT 2022, 165, 113705. [Google Scholar] [CrossRef]
- Li, Q.; Ren, T.; Perkins, P. The development and application of nanocomposites with pH-sensitive “gates” to control the release of active agents: Extending the shelf-life of fresh wheat noodles. Food Control 2022, 132, 108563. [Google Scholar] [CrossRef]
- Gao, F.; Zhou, H.; Shen, Z.; Zhu, G.; Hao, L.; Chen, H.; Xu, H.; Zhou, X. Long-lasting anti-bacterial activity and bacteriostatic mechanism of tea tree oil adsorbed on the amino-functionalized mesoporous silica-coated by PAA. Colloids Surf B Biointerfaces 2020, 188, 110784. [Google Scholar] [CrossRef] [PubMed]
- Wang, J.Y.; Zhang, W.J.; Tang, C.E.; Xiao, J.; Xie, B.J.; Sun, Z.D. Synergistic effect of B-type oligomeric procyanidins from lotus seedpod in combination with water-soluble Poria cocos polysaccharides against E. coli and mechanism. J. Funct. Foods 2018, 48, 134–143. [Google Scholar] [CrossRef]
- Zong, R.; Ruan, H.; Zhu, W.; Zhang, P.; Feng, Z.; Liu, C.; Fan, S.; Liang, H.; Li, J. Curcumin nanocrystals with tunable surface zeta potential: Preparation, characterization and antibacterial study. J. Drug Deliv. Sci. Technol. 2022, 76, 103771. [Google Scholar] [CrossRef]
- Kosmulski, M.; Mączka, E. Zeta potential and particle size in dispersions of alumina in 50–50 w/w ethylene glycol-water mixture. Colloid Surf. A 2022, 654, 130168. [Google Scholar] [CrossRef]
- Pena-Gomez, N.; Ruiz-Rico, M.; Perez-Esteve, E.; Fernandez-Segovia, I.; Barat, J.M. Novel antimicrobial filtering materials based on carvacrol, eugenol, thymol and vanillin immobilized on silica microparticles for water treatment. Innov. Food Sci. Emerg. Technol. 2019, 58, 102228. [Google Scholar] [CrossRef]
- Brar, A.; Majumder, S.; Navarro, M.Z.; Benoit-Biancamano, M.O.; Ronholm, J.; George, S. Nanoparticle-Enabled Combination Therapy Showed Superior Activity against Multi-Drug Resistant Bacterial Pathogens in Comparison to Free Drugs. Nanomaterials 2022, 12, 2179. [Google Scholar] [CrossRef] [PubMed]
- Ruiz-Rico, M.; Perez-Esteve, E.; Bernardos, A.; Sancenon, F.; Martinez-Manez, R.; Marcos, M.D.; Barat, J.M. Enhanced antimicrobial activity of essential oil components immobilized on silica particles. Food Chem. 2017, 233, 228–236. [Google Scholar] [CrossRef]
- Hou, J.J.; Xia, J.T.; Weng, R.Y.; Liu, Y.T.; Li, L.Y.; Liu, K.Y.; Sheng, J.; Song, Y.S. Mesoporous silicon extracted from rice husk for remediation of different sorts of dyestuffs from simulated textile effluent: Kinetic, isotherm, and mechanism study. Biomass Convers. Biorefin. 2022, 1–14. [Google Scholar] [CrossRef]
- Hou, J.J.; Weng, R.Y.; Jiang, W.W.; Sun, H.M.; Xia, J.T.; Liu, Y.T.; Sheng, J.; Song, Y.S. In-situ preparation of novel sedimentary rock-like Fe3O4 by rice-husk mesoporous silica as templates for effective remove As(III) from aqueous solutions. J. Environ. Chem. Eng. 2021, 9, 105866. [Google Scholar] [CrossRef]
- Paramanantham, P.; Antony, A.P.; Sruthil Lal, S.B.; Sharan, A.; Syed, A.; Ahmed, M.; Alarfaj, A.A.; Busi, S.; Maaza, M.; Kaviyarasu, K. Antimicrobial photodynamic inactivation of fungal biofilm using amino functionalized mesoporus silica-rose bengal nanoconjugate against Candida albicans. Sci. Afr. 2018, 1, e00007. [Google Scholar] [CrossRef]
- Dai, X.X.; Qiu, F.G.; Zhou, X.; Long, Y.M.; Li, W.F.; Tu, Y.F. Amino-functionalized mesoporous silica modified glassy carbon electrode for ultra-trace copper(II) determination. Anal. Chim. Acta 2014, 848, 25–31. [Google Scholar] [CrossRef] [PubMed]
- Tian, H.; Lu, Z.; Li, D.; Hu, J. Preparation and characterization of citral-loaded solid lipid nanoparticles. Food Chem. 2018, 248, 78–85. [Google Scholar] [CrossRef] [PubMed]
- Li, J.; Liu, X.; Bian, C.; Sheng, J.; Song, Y.; Zhu, Y. Fabrication linalool-functionalized hollow mesoporous silica spheres nanoparticles for efficiently enhance bactericidal activity. Chin. Chem. Lett. 2020, 31, 2137–2141. [Google Scholar]
- Xu, Y.; Chen, L.; Zhang, Y.; Huang, Y.; Cao, J.; Jiang, W. Antimicrobial and controlled release properties of nanocomposite film containing thymol and carvacrol loaded UiO-66-NH2 for active food packaging. Food Chem. 2022, 404, 134427. [Google Scholar] [CrossRef] [PubMed]
- Chen, F.; Guo, M.; You, L.; Dong, H.; Ding, G.; Zhang, W.; Gang, T.; Yang, J.; Kong, D.; Cao, Y. Pectin-conjugated silica microcapsules as dual-responsive carriers for increasing the stability and antimicrobial efficacy of kasugamycin. Carbohyd. Polym. 2017, 172, 322–331. [Google Scholar]
- Thommes, M.; Kaneko, K.; Neimark, A.V.; Olivier, J.P.; Rodriguez-Reinoso, F.; Rouquerol, J.; Sing, K.S.W. Physisorption of gases, with special reference to the evaluation of surface area and pore size distribution (IUPAC Technical Report). Pure Appl. Chem. 2015, 87, 1051–1069. [Google Scholar] [CrossRef]
- Hou, J.J.; Liu, Y.H.; Weng, R.Y.; Li, L.Y.; Liu, Y.T.; Sheng, J.; Song, Y.S. Purification of dye-contaminated water using Si-doped mesoporous Fe3O4 prepared with rice husk SBA-15 as a template: Behavior and mechanism. Biomass Convers. Biorefin. 2022, 1–15. [Google Scholar] [CrossRef]
- Diaz-Garcia, D.; Ardiles, P.R.; Diaz-Sanchez, M.; Mena-Palomo, I.; Del Hierro, I.; Prashar, S.; Rodriguez-Dieguez, A.; Paez, P.L.; Gomez-Ruiz, S. Copper-functionalized nanostructured silica-based systems: Study of the antimicrobial applications and ROS generation against gram positive and gram negative bacteria. J. Inorg. Biochem. 2020, 203, 110912. [Google Scholar] [CrossRef] [PubMed]
- Marinescu, G.; Culita, D.C.; Romanitan, C.; Somacescu, S.; Ene, C.D.; Marinescu, V.; Negreanu, D.G.; Maxim, C.; Popa, M.; Marutescu, L.; et al. Novel hybrid materials based on heteroleptic Ru(III) complexes immobilized on SBA-15 mesoporous silica as highly potent antimicrobial and cytotoxic agents. Appl. Surf. Sci. 2020, 520, 146379. [Google Scholar] [CrossRef]
- Jangra, S.; Devi, S.; Tomer, V.K.; Chhokar, V.; Duhan, S. Improved antimicrobial property and controlled drug release kinetics of silver sulfadiazine loaded ordered mesoporous silica. J. Asian Ceram. Soc. 2016, 4, 282–288. [Google Scholar] [CrossRef]
- Pan, F.; Giovannini, G.; Zhang, S.; Altenried, S.; Zuber, F.; Chen, Q.; Boesel, L.F.; Ren, Q. pH-responsive silica nanoparticles for the treatment of skin wound infections. Acta Biomater. 2022, 145, 172–184. [Google Scholar] [CrossRef]
- Bhaskara Rao, B.V.; Mukherji, R.; Shitre, G.; Alam, F.; Prabhune, A.A.; Kale, S.N. Controlled release of antimicrobial Cephalexin drug from silica microparticles. Mater. Sci. Eng. C Mater. Biol. Appl. 2014, 34, 9–14. [Google Scholar] [CrossRef]
- Carucci, C.; Sechi, G.; Piludu, M.; Monduzzi, M.; Salis, A. A drug delivery system based on poly-L-lysine grafted mesoporous silica nanoparticles for quercetin release. Colloids Surf. A-Physicochem. Eng. Asp. 2022, 648, 129343. [Google Scholar] [CrossRef]
- Soltanzadeh, M.; Peighambardoust, S.H.; Ghanbarzadeh, B.; Mohammadi, M.; Lorenzo, J.M. Chitosan nanoparticles encapsulating lemongrass (Cymbopogon commutatus) essential oil: Physicochemical, structural, antimicrobial and in-vitro release properties. Int. J. Biol. Macromol. 2021, 192, 1084–1097. [Google Scholar] [CrossRef]
- Zhao, D.; Wei, Y.; Jin, Q.; Yang, N.; Yang, Y.; Wang, D. PEG-Functionalized Hollow Multishelled Structures with On-Off Switch and Rate-Regulation for Controllable Antimicrobial Release. Angew. Chem. Int. Ed. 2022, 61, e202206807. [Google Scholar] [CrossRef]
- Jadhav, R.; Pawar, P.; Choudhari, V.; Topare, N.; Raut-Jadhav, S.; Bokil, S.; Khan, A. An overview of antimicrobial nanoparticles for food preservation. Mater. Today Proc. 2022. [Google Scholar] [CrossRef]
- Dey, A.; Pandey, G.; Rawtani, D. Functionalized nanomaterials driven antimicrobial food packaging: A technological advancement in food science. Food Control 2022, 131, 108469. [Google Scholar] [CrossRef]
- Liu, J.; Li, S.; Fang, Y.; Zhu, Z. Boosting antibacterial activity with mesoporous silica nanoparticles supported silver nanoclusters. J. Colloid Interface Sci. 2019, 555, 470–479. [Google Scholar] [CrossRef] [PubMed]
- Jin, L.; Teng, J.; Hu, L.; Lan, X.; Xu, Y.; Sheng, J.; Song, Y.; Wang, M. Pepper fragrant essential oil (PFEO) and functionalized MCM-41 nanoparticles: Formation, characterization, and bactericidal activity. J. Sci. Food Agric. 2019, 99, 5168–5175. [Google Scholar] [CrossRef] [PubMed]
- Pandey, R.P.; Mukherjee, R.; Priyadarshini, A.; Gupta, A.; Vibhuti, A.; Leal, E.; Sengupta, U.; Katoch, V.M.; Sharma, P.; Moore, C.E.; et al. Potential of nanoparticles encapsulated drugs for possible inhibition of the antimicrobial resistance development. Biomed. Pharm. 2021, 141, 111943. [Google Scholar] [CrossRef]
- Lu, W.W.; Cui, R.; Zhu, B.F.; Qin, Y.Y.; Cheng, G.G.; Li, L.; Yuan, M.L. Influence of clove essential oil immobilized in mesoporous silica nanoparticles on the functional properties of poly(lactic acid) biocomposite food packaging film. J. Mater. Res. Technol. 2021, 11, 1152–1161. [Google Scholar] [CrossRef]
- Firmanda, A.; Fahma, F.; Warsiki, E.; Syamsu, K.; Arnata, I.W.; Sartika, D.; Suryanegara, L.; Qanytah; Suyanto, A. Antimicrobial mechanism of nanocellulose composite packaging incorporated with essential oils. Food Control 2023, 147, 109617. [Google Scholar] [CrossRef]
- Dhifi, W.; Bellili, S.; Jazi, S.; Bahloul, N.; Mnif, W. Essential Oils’ Chemical Characterization and Investigation of Some Biological Activities: A Critical Review. Medicines 2016, 3, 25. [Google Scholar] [CrossRef]

| Materials | Surface Area (m2/g) | Average Pore Diameter (nm) | Pore Volume (m3/g) | Zeta Potential (mV) | The Average Size (nm) |
|---|---|---|---|---|---|
| HMSS | 885.12 | 3.186 | 0.705 | −12.0 | 616 |
| M-NH2 | 368.26 | 3.067 | 0.393 | 25.4 | 627 |
| M-NH2-CIT@CIT | 268.73 | 3.024 | 0.203 | 24.5 | 634 |
Disclaimer/Publisher’s Note: The statements, opinions and data contained in all publications are solely those of the individual author(s) and contributor(s) and not of MDPI and/or the editor(s). MDPI and/or the editor(s) disclaim responsibility for any injury to people or property resulting from any ideas, methods, instructions or products referred to in the content. |
© 2023 by the authors. Licensee MDPI, Basel, Switzerland. This article is an open access article distributed under the terms and conditions of the Creative Commons Attribution (CC BY) license (https://creativecommons.org/licenses/by/4.0/).
Share and Cite
Lu, Y.; Li, X.; Xu, J.; Sun, H.; Sheng, J.; Song, Y.; Chen, Y. Utilizing Imine Bonds to Create a Self-Gated Mesoporous Silica Material with Controlled Release and Antimicrobial Properties. Nanomaterials 2023, 13, 1384. https://doi.org/10.3390/nano13081384
Lu Y, Li X, Xu J, Sun H, Sheng J, Song Y, Chen Y. Utilizing Imine Bonds to Create a Self-Gated Mesoporous Silica Material with Controlled Release and Antimicrobial Properties. Nanomaterials. 2023; 13(8):1384. https://doi.org/10.3390/nano13081384
Chicago/Turabian StyleLu, Yuyang, Xutao Li, Jiaqi Xu, Huimin Sun, Jie Sheng, Yishan Song, and Yang Chen. 2023. "Utilizing Imine Bonds to Create a Self-Gated Mesoporous Silica Material with Controlled Release and Antimicrobial Properties" Nanomaterials 13, no. 8: 1384. https://doi.org/10.3390/nano13081384
APA StyleLu, Y., Li, X., Xu, J., Sun, H., Sheng, J., Song, Y., & Chen, Y. (2023). Utilizing Imine Bonds to Create a Self-Gated Mesoporous Silica Material with Controlled Release and Antimicrobial Properties. Nanomaterials, 13(8), 1384. https://doi.org/10.3390/nano13081384
